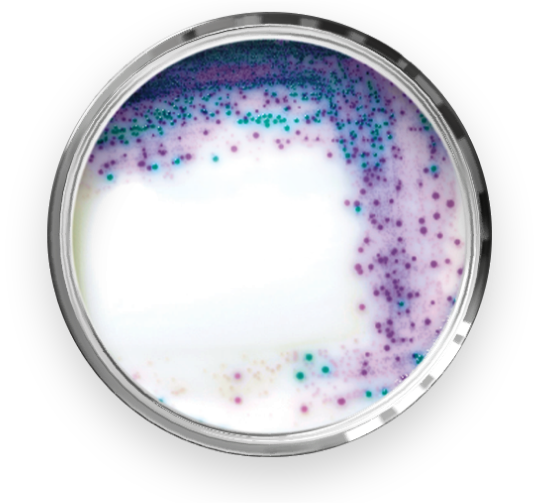
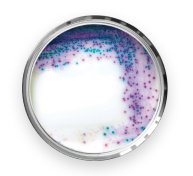

Descubra a linha RAPID'

A revolução em testes microbiológicos para a indústria de alimentos!
O RAPID’Salmonella é um meio de cultura cromogênico sensível usado para a detecção e enumeração de Salmonella spp. em produtos para consumo humano e animal.
CONHEÇA AGORA O
RAPID'Salmonella
Transforme a produtividade da sua rotina de análises com confiança!
Agilidade sem precedentes
Esqueça a autoclavagem! Com o RAPID'Salmonella, você economiza tempo e esforço, obtendo resultados de qualidade em apenas 2-3 dias, do enriquecimento à confirmação. Você vai ganhar rapidez e eficiência na sua rotina de análise, mantendo a excelência dos testes.
Leitura simplificada, interpretação confiável
As características cromogênicas deste meio de cultura tornam a leitura e interpretação dos resultados tão fáceis como 1, 2, 3! Seja você um especialista ou um iniciante, o RAPID'Salmonella garante resultados claros e precisos.
Comprovação total com validação AFNOR
O RAPID'Salmonella é respaldado por padrões rigorosos, sendo validado pela renomada certificação internacional AFNOR. Você terá total confiança nos resultados, atendendo às principais legislações e exigências do setor.
Validação ISO 6579
Validado na ISO 6579 como meio secundário para etapa de isolamento seletivo.
Integre o RAPID'Salmonella
em sua rotina
Adote o RAPID’Salmonella como método principal ou como método confirmatório em associação aos kits iQ-Check. A flexibilidade do RAPID’Salmonella se adapta às suas necessidades, otimizando seus processos e resultados.

NÃO PERCA TEMPO
Solicite um orçamento para o RAPID’Salmonella e garanta resultados confiáveis e rápidos para sua rotina de análise de alimentos.
Estamos prontos para atender suas demandas!

Parceria perfeita com o iQ-Check Salmonella
Potencialize ainda mais sua análise! Ao utilizar o RAPID’Salmonella em conjunto com o iQ-Check Salmonella, você alcança um método confirmatório robusto, aumentando a agilidade de liberação dos resultados e com a confiança que seu laboratório precisa.
Condições promocionais imperdíveis!

Conheça nossas ofertas especiais e condições exclusivas para a linha RAPID. Aproveite essa oportunidade única para elevar sua análise de segurança de alimentos a um novo patamar.
Por que confiar nas soluções para análise de alimentos oferecidas pela Bio-Rad?
Porque sabemos muito bem do que estamos falando! Confira você mesmo:

CARTILHA
CONTEÚDO EXCLUSIVO
RAPID’Salmonella
Baixe grátis nossa cartilha
e desvende o RAPID’Salmonella.

WEBINAR
“Otimização do workflow de análises microbiológicas a partir da cultura tradicional”
Descubra os segredos para agilizar suas análises de alimentos! Você está pronto(a) para elevar suas análises microbiológicas a um novo patamar de eficiência? Desbloqueie gratuitamente seu acesso ao Webinar, com o expert Marcelo Silva, e repense a produtividade dos seu fluxo de trabalho com ajuda de um especialista!

CURSO
UNIVERSIDADE BIO-RAD
Segurança dos Alimentos
Inscreva-se no curso da Universidade Bio-Rad e garanta seu certificado gratuitamente. São dois módulos repletos de conhecimentos técnicos e científicos em conceitos atuais da Segurança dos Alimentos, principalmente no nicho de análises microbiológicas, com aulas dinâmicas preparadas por experts da Bio-Rad, mestres e doutores em diferentes áreas da Ciência.

MATÉRIA
PORTAL FEED & FOOD
Pesquisa de Salmonella spp demanda assertividade
Você sabe qual é a importância da assertividade na pesquisa de Salmonella spp? Confira a matéria do Feed Food sobre a evolução das opções de testes disponíveis no mercado para pesquisa deste patógeno.
Aproveite as condições promocionais!

Quero conhecer as condições especiais!
Entre em contato conosco hoje mesmo e descubra os benefícios do RAPID’Salmonella da Bio-Rad.
A inovação em detecção rápida está ao seu alcance.
